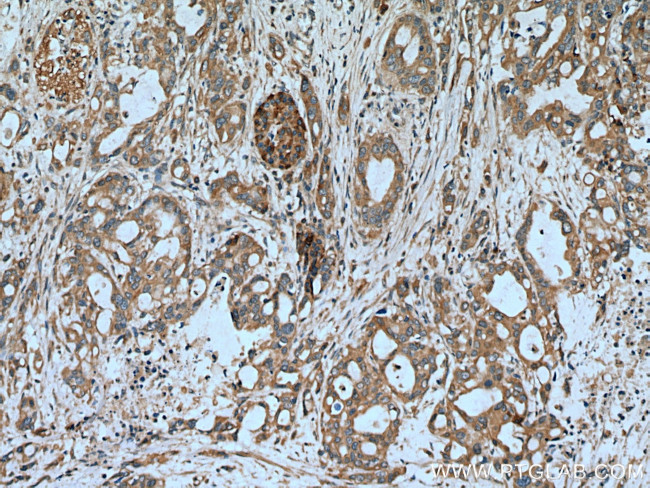
ASIC1 Antibody in Immunohistochemistry (Paraffin) (IHC (P))
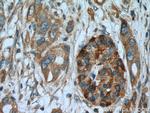
ASIC1 Antibody in Immunohistochemistry (Paraffin) (IHC (P))

Search
Proteintech
ASIC1 Polyclonal Antibody
{{$productOrderCtrl.translations['antibody.pdp.commerceCard.promotion.promotions']}}
{{$productOrderCtrl.translations['antibody.pdp.commerceCard.promotion.viewpromo']}}
{{$productOrderCtrl.translations['antibody.pdp.commerceCard.promotion.promocode']}}: {{promo.promoCode}} {{promo.promoTitle}} {{promo.promoDescription}}. {{$productOrderCtrl.translations['antibody.pdp.commerceCard.promotion.learnmore']}}
产品信息
27235-1-AP
种属反应
已发表种属
宿主/亚型
分类
类型
抗原
偶联物
形式
浓度
规格
纯化类型
保存液
内含物
保存条件
运输条件
产品详细信息
Immunogen sequence: MKLCRRGKC QKEAKRSSAD KGVALSLDDV KRHNPCESLR GHPAGMTYAA NILPHHPARG TFEDFTC (464-528 aa encoded by NM_001095)
靶标信息
This gene encodes a member of the degenerin/epithelial sodium channel (DEG/ENaC) superfamily. The members of this family are amiloride-sensitive sodium channels that contain intracellular N and C termini, 2 hydrophobic transmembrane regions, and a large extracellular loop, which has many cysteine residues with conserved spacing. The member encoded by this gene is expressed in most if not all brain neurons, and it may be an ion channel subunit; however, its function as an ion channel remains unknown. Cation channel with high affinity for sodium, which is gated by extracellular protons and inhibited by the diuretic amiloride. ASIC1 is permeable for Ca(2+), Li(+) and K(+) and is expressed in dorsal root ganglia, sciatic nerves, olfactory bulb, neo and allocortical regions, dentate granule cells, pyramidal cells of CA1-CA3 subfields of the hippocampal formation, habenula, basolateral amygdaloid nuclei, and in the Purkinje and granule cells of the cerebellum. It is diffusely detected over most other regions of the basal ganglia, including thalamic nuclei, substantia nigra, striatum and globus pallidus, hypothalamus, midbrain, pons, medulla and choroid plexus. Isoform 3 is expressed only in dorsal root ganglion while isoform 1 is expressed in DRG, spinal chord, trigeminal ganglia and the trigeminal mesencephalic nucleus.
仅用于科研。不用于诊断过程。未经明确授权不得转售。
生物信息学
蛋白别名: ACCN2 variant 3; acid sensing (proton gated) ion channel 1; acid sensing ion channel; Acid-sensing ion channel; Acid-sensing ion channel 1; acid-sensing ion channel 1a protein; Acid-sensing ionic channel; Amiloride-sensitive cation channel 2, neuronal; ASIC; ASIC1; BNaC2; Brain sodium channel 2; Cation channel, amiloride-sensitive, neuronal, 2; degenerin 2; hBNaC2; proton gated cation channel ASIC1; unnamed protein product
基因别名: ACCN2; AI843610; ASIC; ASIC1; ASIC1a; B530003N02Rik; BNAC2
UniProt ID: (Human) P78348, (Mouse) Q6NXK8, (Rat) P55926
Entrez Gene ID: (Human) 41, (Mouse) 11419, (Rat) 79123